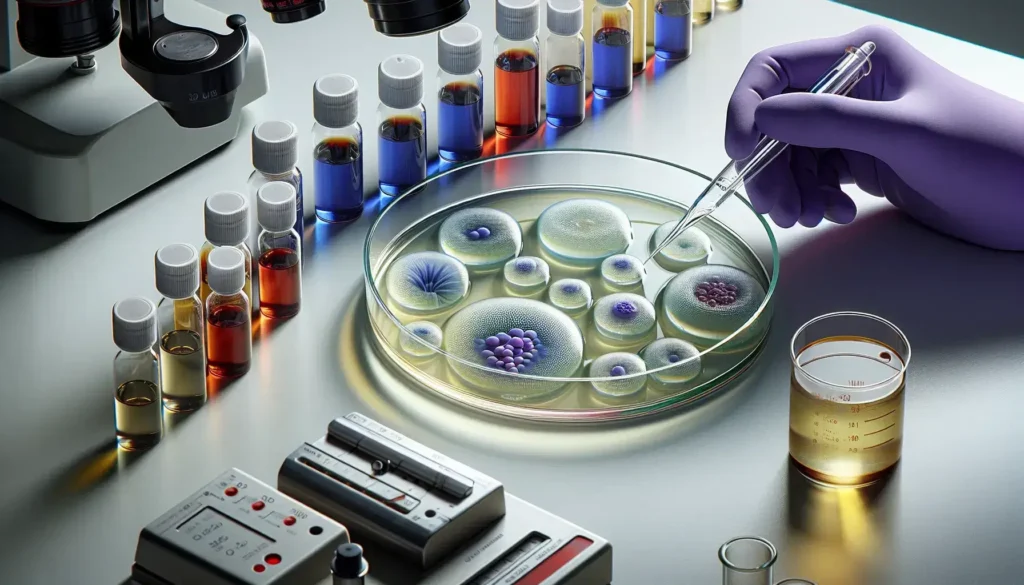

Nutrición, ambiente y productividad en hembras reproductoras: ¿cómo se relacionan?
Por MSc. Santiago Capalbo, Director Técnico Bioter S.A. La producción porcina contemporánea enfrenta un doble desafío: maximizar el potencial genético y la creciente incidencia del estrés térmico debido al cambio climático global, incluso en países templados. Las cerdas, seleccionadas por su capacidad de deposición de músculo y prolificidad, producen un 16% más de calor metabólico que hace tres […]Leer más